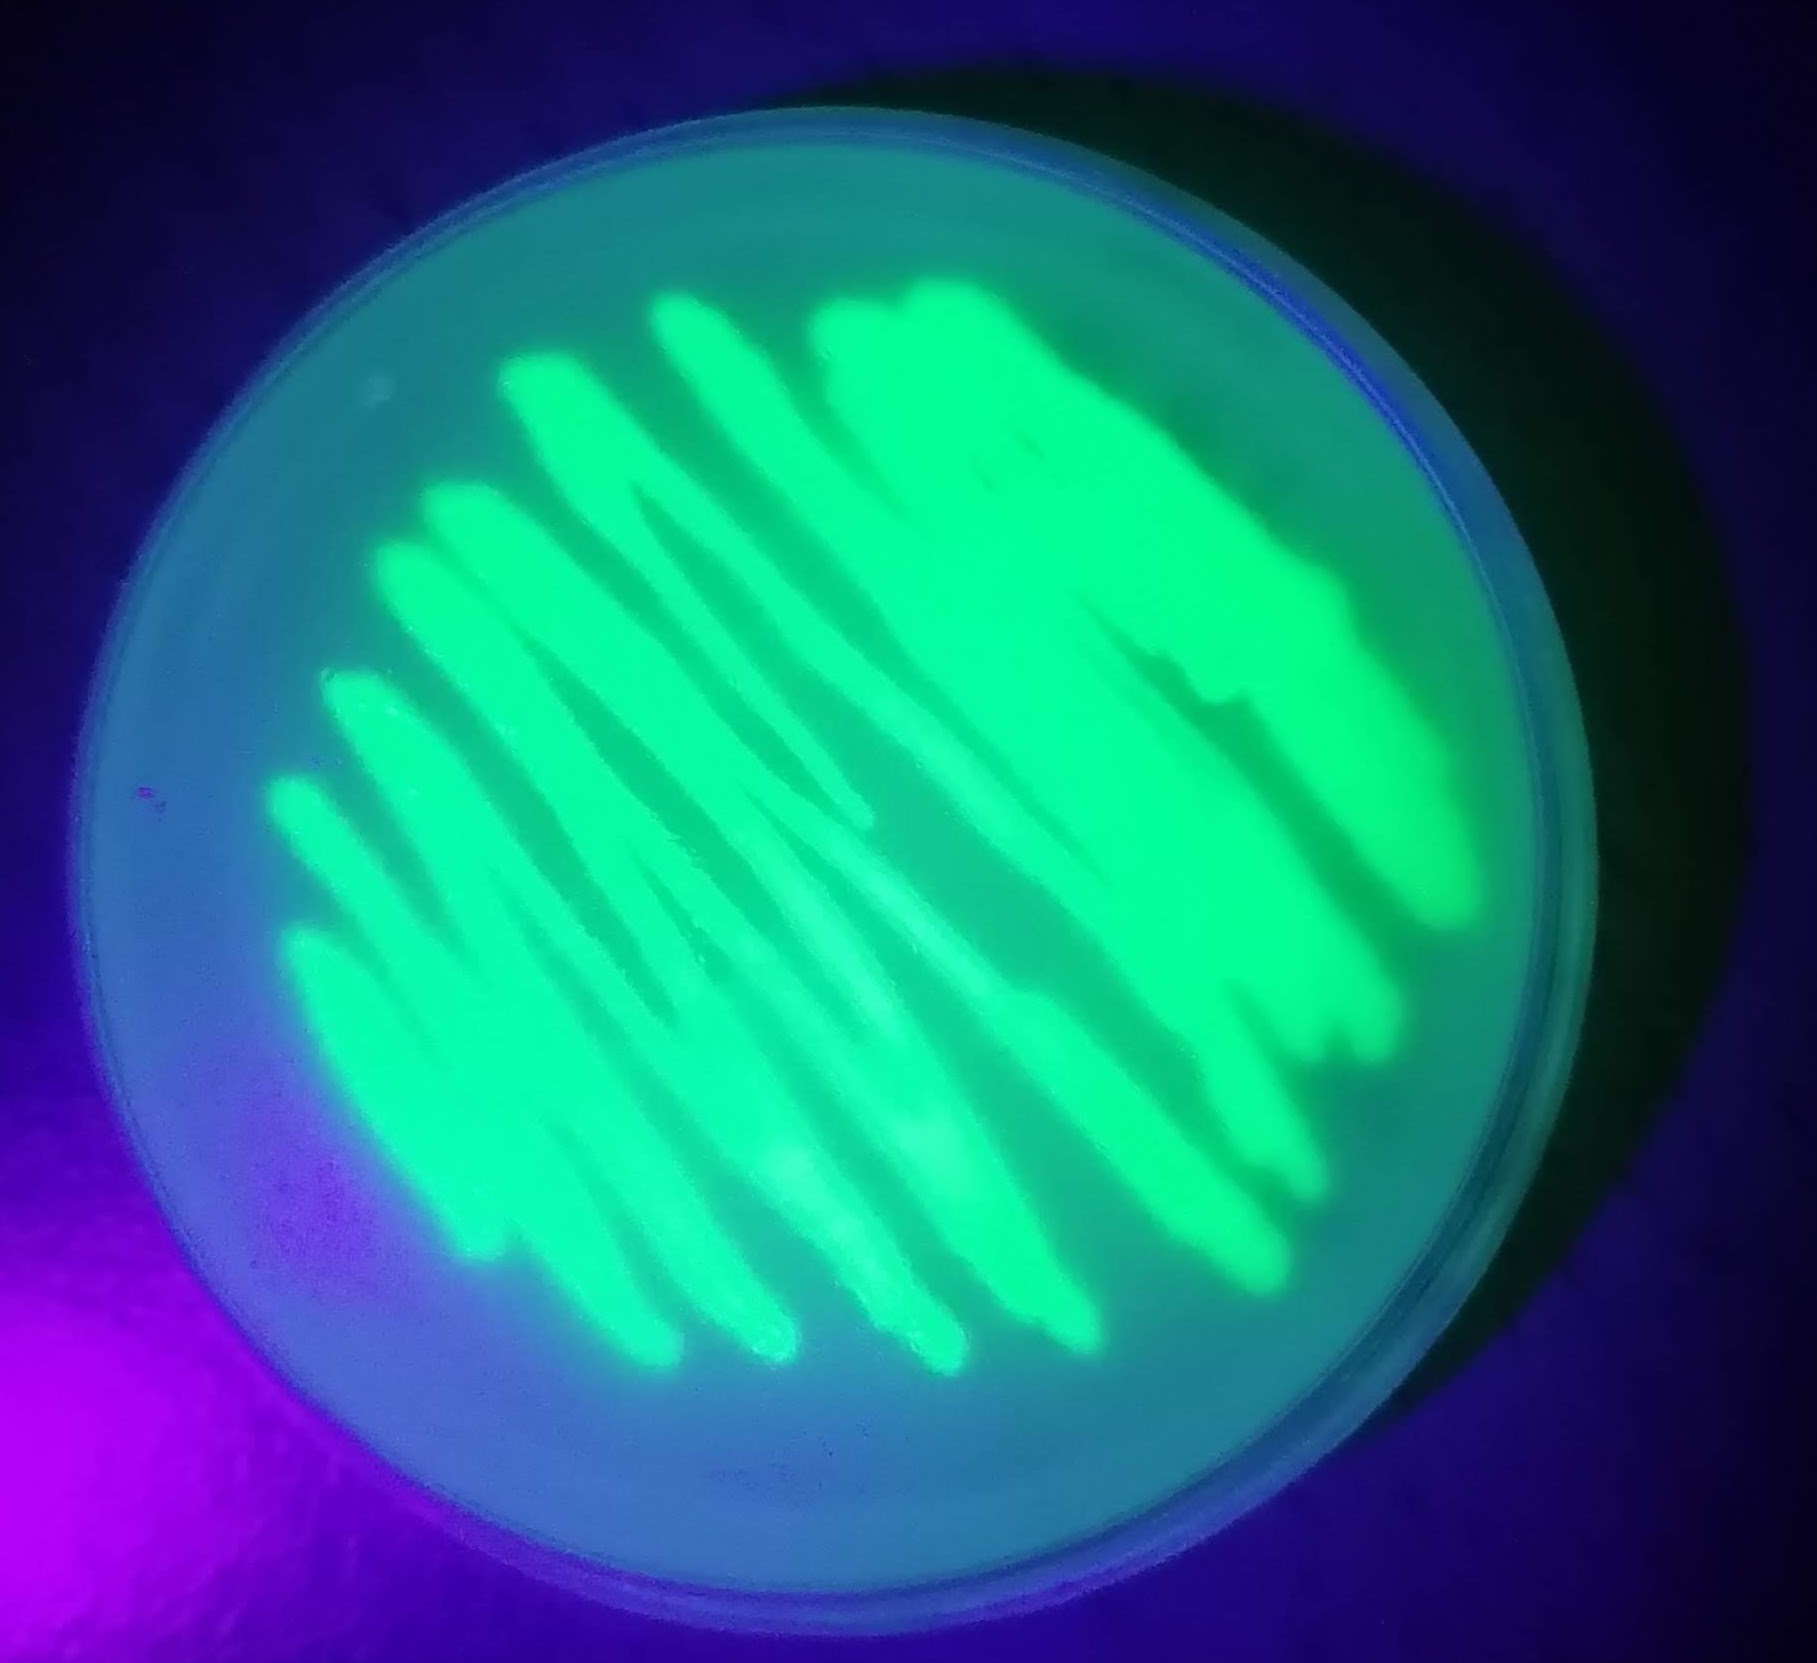

Biotecnología Fácil
Lleva la biotecnología a tu aula
Proyectos altamente motivadores
Bacterias fluorescentes, barcoding de ADN, PCR, métodos isotérmicos, bioreactores y más.



¡Revoluciona tu aula!
En todos los proyectos…
Bacterias fluorescentes, barcoding de ADN, PCR, métodos isotérmicos, bioreactores y más.

En todos los proyectos…